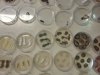
ND_9r_Mikrobiologija-biotehnologija_202607

Najprej smo se učili o bakterijah in virusih ter spoznali nekaj osnov o tem, kako delujejo. Nato smo delali kvasne bombice. Sledilo je predavanje o biotehnologiji, kjer smo izvedeli, kako se gensko spremenjeni organizmi uporabljajo v znanosti in industriji. Na koncu smo uporabljali mikroskop, da smo lahko opazovali različne predmete in plesni ter s pomočjo lego kock usvojili, kako na ribosomih poteka sinteza beljakovin.
Po mojem mnenju je bil to eden najboljših naravoslovnih dni, res se mi je zdel zanimiv in zabaven.
Lovro Tušek, 9. a
V ponedeljek, 2. 3. 2026, smo učenci 9. razreda imeli naravoslovni dan na temo mikrobiologije in biotehnologije. Na šoli sta nas obiskala predstavnika Mikrobiologije Avberšek.
Prvo uro smo imeli skupno predavanje o mikrobiologiji. Drugo in tretjo uro pa smo se razdelili po razredih in izvajali eksperiment Kvasne bombice, ki nam je bil zelo všeč, in pod mikroskopom opazovali razne žuželke, školjke, plesni …
Izvedli smo tudi interaktivno igro ribosom: prevod iz DNA v protein – z lego kockami. Dan smo zaključili s predavanjem o biotehnologiji.
Erika Demšar, 9. b